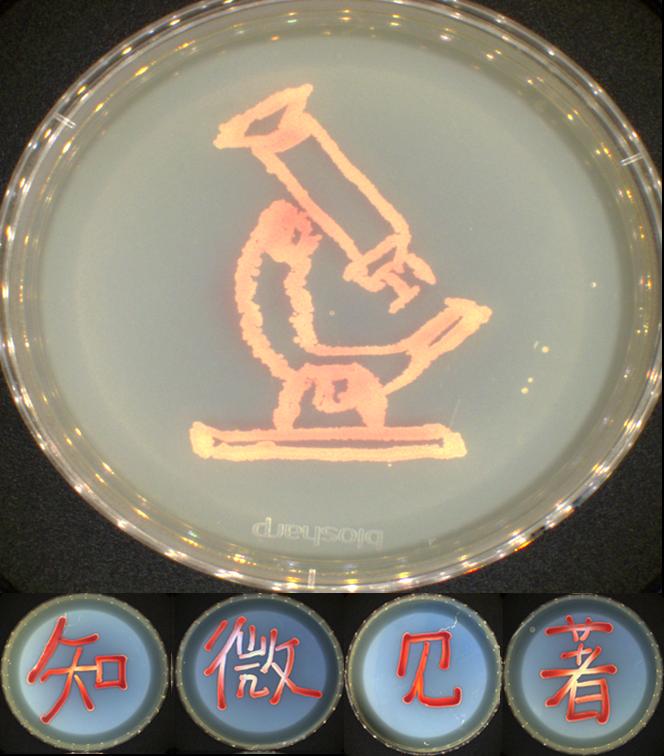

為深入宣傳貫徹習近平總書記在《生物多樣性公約》第十五次締約方大會主旨講話精神,激發微生物領域科研人員工作熱情,發現微生物多樣性和神奇美妙,提升會員學術論文插圖質量水平,增加科普素材,由新疆微生物學會舉辦的“知微見著”微生物攝影大賽于2022年2月10日圓滿落幕。
圖1 作品“知微見著”(徐李娟 新疆農業科學院微生物應用研究所提供)
學會理事長郭文超研究員在本次攝影大賽中指出:“微生物與人類社會生活和生產密切相關,然而由于它極其微小,我們每天可以接觸到、使用到,但卻不知到它是什么樣,通過這樣富有創意的攝影比賽,可以讓大家了解微生物,看到微生物,發現它的美,探索它的用途,讓更多的人投身到微生物學科的研究、應用和科普工作中”。

圖2 作品“日出東方”(張志東 新疆農業科學院微生物應用研究所提供)
攝影大賽得到了學會會員的積極參與和踴躍投稿,共收到來自科研院所、大學及基層單位11家70余位作者的100余幅(組)特色鮮明、創意突出的作品,內容涉及新發現的微生物屬種、病原微生物和食品微生物的顯微攝影、科普圖片以及創意攝影等。通過評審專家認真評選,最終優選出王麗麗、朱靜等44份獲獎作品,活動有效促進了學會會員間的學術交流,進一步豐富了學會的科普素材。

圖3 作品“中國黃花柳柵銹菌”(王麗麗 新疆農業大學提供)

圖4 作品“2022新年快樂”(巴哈提古麗·馬那提拜 烏魯木齊海關技術中心提供)
創意攝影優秀獎獲得者烏魯木齊海關技術中心巴哈提古麗·馬那提拜研究員說:“感謝微生物學會舉辦的這次活動,開年之際,有機會用自己工作中色彩豐富、形態各異的微生物作圖送上新年祝福,并被我們微生物界知名專家用來道賀新年,是我們科研人員特有的浪漫,感覺特別幸福!”
顯微攝影二等獎獲得者新疆農業科學院微生物應用研究所朱靜研究員說:“新疆擁有豐富多樣的微生物資源,蘊含著大量的微生物新類群有待我們發現。本次參展的組圖是我們從鹽堿土壤中從離鑒定的一株小克銀漢霉屬新物種,這次比賽不僅有機會把自己最新成果與大家分享,而且也結識了更多微生物學專家,大家相互勉勵,相互交流學習,收獲很大,希望學會能多舉辦此類活動。”

圖5 作品“小克銀漢霉新物種”(朱靜 新疆農業科學院微生物應用研究所提供)
此次攝影大賽也收集到了內容豐富的科普素材,有微觀世界下形態各異的微生物,如梨火疫病原菌侵染香梨葉片后在葉脈中遷移擴展動態掃描電鏡圖;有我區豐富多樣的大型真菌資源毒蘑菇圖集;有照片記錄的被真菌逐步侵染的玉米螟僵蟲;有長在培養皿中盛開的“花簇”。同時,本次大賽也激發了青年科技工作者的創作熱情,他們利用豐富多彩的微生物大膽構圖,創作出了一幅幅愛黨、愛國、愛疆的美麗畫卷,充分展現出了我區青年一代“四個自信”的時代風采。

圖6 作品“紅綬曲霉侵染的玉米螟”(王小武 新疆農業科學院微生物應用研究所提供)

圖7 部分獲獎優秀作品圖集
此次大賽,有效調動了學會會員科普積極性,他們以微生物為筆,用藝術思想勾勒出了科學之美,為微生物學科知識普及做出了貢獻,展現出了較高的科學素養。一幅幅優秀的作品,也充分體現了會員們扎根邊疆建設祖國,“干一行、鉆一行、愛一行”的精神風貌,這種愛國愛疆精神必將引領我區微生物學科技工作者們為自治區高質量發展貢獻智慧和力量,持續為鄉村振興建設提供動力引擎。
責任編輯:桑格林 審核:艾斯克爾·臺外庫力
新疆微生物學會 易鴛鴦 供稿